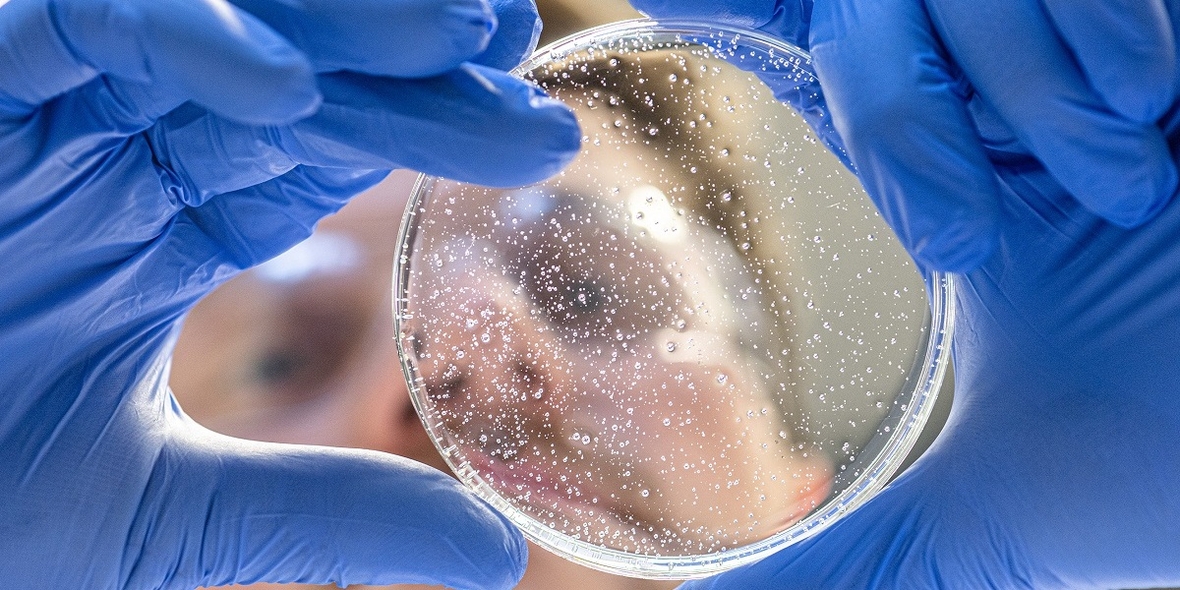

Verfahren könnte Edelmetalle bei der Silikonproduktion ersetzen
Silicone haben sich im privaten und im professionellen Bereich bewährt. Damit aus dem flüssigen Vorprodukt das elastische und haltbare Polymer wird, benötigt man jedoch in vielen Fällen teure Edelmetalle als Katalysatoren. Einem Forschungsteam der Technischen Universität München (TUM) und des Münchner WACKER-Konzerns ist es nun gelungen, einen Vernetzungsprozess zu entwickeln, der ohne Edelmetalle auskommt.
19.01.2021
Als Silicone bezeichnet man synthetische Polymere, die aus einem anorganischen und durch organische Reste modifizierten Silicium-Sauerstoff-Grundgerüst bestehen. Vor der Verwendung wird das Silicon durch chemische Vernetzung in einen gummielastischen Zustand überführt.
Von den industriell genutzten Verfahren hat vor allem die Additionsvernetzung große Bedeutung, da der Vernetzungsprozess keine Spaltprodukte freisetzt und die Herstellung von besonders hochwertigen Silicon-Elastomeren ermöglicht.
Das Verfahren hat allerdings einen Nachteil: Die zur Vernetzung benötigten Katalysatoren enthalten Edelmetalle wie etwa Platin, was die Herstellung relativ teuer macht. Zudem verbleiben die Edelmetalle dauerhaft im Silicon.
Gespannte Ringe statt Edelmetall
Einen vielversprechenden Ansatz zur Lösung dieses Problems hat nun ein Forschungsteam unter der Leitung von Professor Bernhard Rieger, Inhaber des WACKER-Lehrstuhls für Makromolekulare Chemie, und Dr. Richard Weidner, zuständig für die Organosilicium-Forschung am Consortium für elektrochemische Industrie, der zentralen Forschungsstätte des WACKER-Konzerns, gefunden.
Den Wissenschaftlern gelang es erstmals, Siliconkautschuke ohne edelmetallhaltige Katalysatoren zu vulkanisieren. Statt der sonst üblichen Vernetzer verwendeten sie dazu Siliconbausteine, die Siliran-Einheiten enthalten.
Silirane sind gespannte und damit reaktive Dreiringe. Sie bestehen aus einem Silicium- und zwei Kohlenstoff-Atomen, die unter Ringöffnung direkt mit geeigneten funktionellen Gruppen ohne Freisetzung von Nebenprodukten reagieren oder durch thermische beziehungsweise photochemische Aktivierung sogenannte Silylene erzeugen können.
Diese hochreaktiven Verbindungen können wiederum mit allen funktionellen Gruppen und Synthesebausteinen reagieren, die bei der Herstellung von Siliconkautschuk üblicherweise eingesetzt werden. Je nach Art der Aktivierung und Wahl der Ausgangsverbindungen lassen sich somit Silicone mit siliranhaltigen Vernetzern auf unterschiedlichen Wegen vernetzen.
Hohe Reinheit
Im Labor konnten die Forscher des WACKER-Instituts nun mit ausgewählten Siliconformulierungen zeigen, dass eine Vernetzung des Siliconkautschuks auf diese Weise möglich ist. Die Endeigenschaften werden dabei allein durch die Wahl der Ausgangsprodukte und deren Mischungsverhältnis bestimmt.
Die auf diese Weise hergestellten Siliconelastomere zeichnen sich durch eine sehr hohe Reinheit aus. Sie enthalten weder flüchtige Substanzen noch Spuren von Edelmetallen. „Das gilt vor allem für Elastomere, die mittels einer Ringöffnung vernetzt wurden. Solche Silicone sind insbesondere für medizinische Einsatzzwecke oder als Vergussmaterialien für die Elektroindustrie geeignet“, sagt Bernhard Rieger.
Nachhaltiger Prozess
Die vorliegende Arbeit ist auch deshalb wegweisend, weil sie erstmals zeigt, wie derartig hochreaktive Siliciumverbindungen für eine industrielle Anwendung prinzipiell nutzbar gemacht werden können. Bis zur Praxistauglichkeit und industriellen Nutzung müssen die Forscher jedoch noch einige Hürden nehmen.
„Die Vorteile des Verfahrens sind aber schon jetzt klar zu erkennen“, sagt Rieger. „Vor dem Hintergrund, dass der Bedarf nach Edelmetallen weltweit steigt, diese aber nur begrenzt zur Verfügung stehen, können alternative Konzepte wie die edelmetallfreie Vernetzung von Silicon mit Hilfe von Siliranen einen wichtigen Beitrag zur Schonung unserer Ressourcen leisten.“
Mehr Informationen:
Die Forschungsarbeit wurde von der Wacker Chemie AG im Rahmen des WACKER-Instituts für Siliciumchemie gefördert. Das am Forschungscampus Garching bei München beheimatete Institut wurde 2006 von der Technischen Universität München und dem Münchner Chemiekonzern WACKER gegründet. Seither haben 54 Forscher des Instituts promoviert. Derzeit erforschen elf Wissenschaftler im Rahmen ihrer Doktorarbeit industriell relevante siliciumorganische Grundlagenthemen. Für die Technologie wurde eine Patentanmeldung eingereicht.


